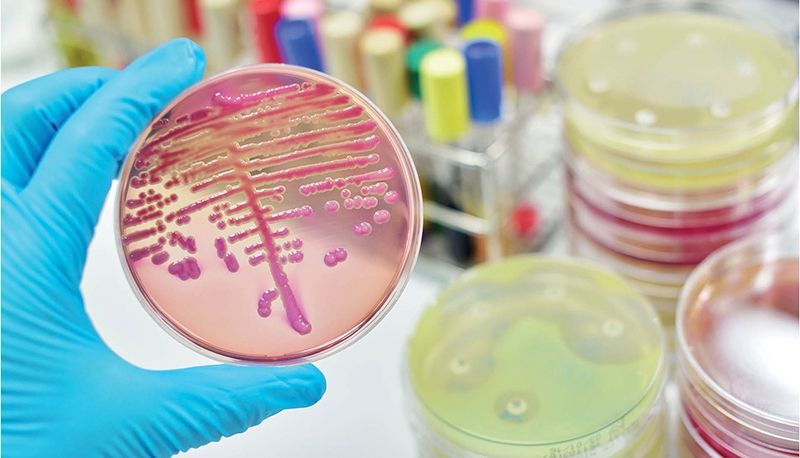

En un esfuerzo por combatir la creciente resistencia a los antibióticos, un grupo de vecinos de Alfara del Patriarca, en Valencia, ha participado en un innovador proyecto de ciencia ciudadana que ha dado como resultado el descubrimiento de seis microorganismos con potencial antibiótico. Este proyecto, denominado ‘Pueblos con-Ciencia’, es una iniciativa de la Universidad CEU Cardenal Herrera (CEU UCH) y ha contado con la colaboración de la Fundación Española de Ciencia y Tecnología (FECYT).
La participación de la comunidad ha sido fundamental en este proceso. Durante el mes de julio, los vecinos recolectaron muestras de tierra de diversas áreas naturales del municipio, incluyendo el barranco del Carraixet y el antiguo convento de San Dídac. A partir de estas muestras, se han analizado un total de 170 cepas de microorganismos, que han sido aisladas y estudiadas en el laboratorio. Este enfoque no solo ha permitido el descubrimiento de nuevos microorganismos, sino que también ha fomentado la educación y la concienciación sobre la resistencia antimicrobiana entre los participantes.
### La Importancia de la Resistencia Antimicrobiana
La resistencia a los antibióticos es un problema de salud pública que ha ido en aumento en las últimas décadas. Según la catedrática de Microbiología de la CEU UCH, Teresa Pérez Gracia, la resistencia antimicrobiana causa más de 23,000 muertes al año en España, lo que representa una cifra alarmante, veinte veces mayor que la de los accidentes de tráfico. A nivel global, se estima que podría convertirse en la principal causa de mortalidad en solo dos décadas si no se toman medidas adecuadas.
El proyecto ‘Pueblos con-Ciencia’ no solo busca identificar nuevos antibióticos, sino también educar a la población sobre el uso responsable de estos medicamentos. Durante las sesiones de trabajo, se han compartido recomendaciones sobre cómo utilizar los antibióticos de manera efectiva y la importancia de seguir las dosis y la duración del tratamiento prescrito. Este enfoque educativo es crucial para frenar el aumento de la resistencia antimicrobiana y asegurar que los antibióticos sigan siendo efectivos en el futuro.
### Un Proyecto Reconocido y Participativo
El proyecto ha sido reconocido por su excelencia, obteniendo la puntuación más alta entre más de 550 propuestas presentadas a la última convocatoria de la FECYT. Desde su inicio en 2017, ‘Pueblos con-Ciencia’ ha involucrado a más de mil jóvenes preuniversitarios y universitarios en la investigación sobre la resistencia antimicrobiana. A través de actividades lúdicas y educativas, como juegos de mesa y escape rooms, se ha logrado captar la atención de los jóvenes y fomentar su interés por la ciencia y la investigación.
La participación activa de la comunidad en la recolección de muestras y el análisis de los microorganismos ha permitido a los vecinos de Alfara del Patriarca sentirse parte de un esfuerzo mayor para abordar un problema de salud global. Este tipo de iniciativas no solo contribuyen al avance de la ciencia, sino que también fortalecen el tejido social y promueven la colaboración entre diferentes sectores de la comunidad.
El apoyo del Ayuntamiento de Alfara del Patriarca ha sido fundamental para el desarrollo de este proyecto. La concejala de Igualdad, Sanidad y Participación Ciudadana, Laura Alandes, junto con el alcalde Jaume Martínez Romero y el primer teniente de alcalde, Jesús Guanter, han impulsado esta colaboración entre la universidad y la comunidad, destacando la importancia de la ciencia ciudadana en la búsqueda de soluciones a problemas contemporáneos.
Los microorganismos identificados en este proyecto se conservarán en los laboratorios de la Facultad de Ciencias de la Salud de la CEU UCH para futuros estudios. Esto abre la puerta a la posibilidad de que estos microorganismos puedan ser utilizados en el desarrollo de nuevos antibióticos que ayuden a combatir infecciones resistentes, un avance que podría tener un impacto significativo en la salud pública.
En resumen, el descubrimiento de estos microorganismos en Alfara del Patriarca es un ejemplo brillante de cómo la ciencia ciudadana puede contribuir a la investigación científica y a la educación sobre temas críticos de salud. La colaboración entre la comunidad y la academia no solo fortalece el conocimiento científico, sino que también empodera a los ciudadanos para que se conviertan en agentes de cambio en la lucha contra la resistencia antimicrobiana.